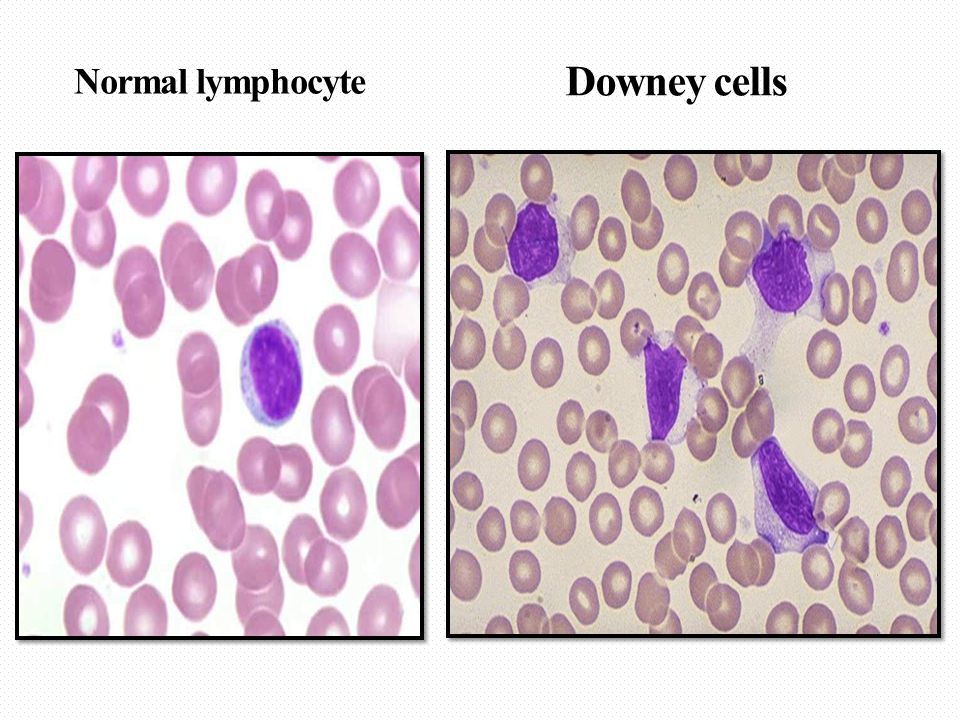

Varför kallas sjukdomen som Epstein Barr-viruset ger upphov till för mononukleos?
- En massiv aktivering och proliferation (celldelning) sker av cytotoxiska CD8 T-celler. Det ökade antalet T-celler leder till ökat antal mononukleära celler i blodet (mononukleära celler inkluderar lymfocyter och monocyter). Vid aktivering och proliferation blir T-cellerna större (lymfoblaster), därav benämningen atypiska lymfocyter.
Hur aktiveras cytokiner vid mononukleos och vad leder de till?
- Cytokiner (från aktiverade T-celler och sekundärt aktiverade monocyter) inkluderar IL-1, IL-6 och tumörnekrotisk faktor (TNF) som påverkar temperaturregleringscentra i hypotalamus och ger feber, också långvarig trötthet
- IL-6 ger illamående
Vad visar bilden?

- Livslång humoral immunitet med antikroppar mot EBV. Först mot det virala kapsidantigenet (VCA) med IgM sedan IgG (livslångt), därefter mot de nukleära antigenen EBNA (efter 6-8 veckor, livslångt).
Hur undkommer EBV NK, CD4+ och CD8+ T-celler och varför kan det aktiveras på nytt?
- Liten fraktion av de infekterade B-cellerna (minnes) elimineras inte, s.k. latent infektion (vilostadium i celler) genom
- utsöndring av vcytokiner (gör miljön mer fördelaktig)
- stör transport till proteasom
- Stör TAP-systemet
- Först vid svårare immunosuppression (t ex vid blodmaligniteter) är viruset farligt. Då kan det utvecklas t.ex. ett polyklonalt B-cells lymfom.
Varför är EBV är ett bra exempel på transformerande onkogena virus?
Virala proteiner ingriper bland annat i det cellcykelkontrollerande Rb (retinoblastomproteinet).
Vad tyder detta på?

- IgM-antikroppar mot EBV, förenligt med aktuell infektion då denna senare försvinner
- De två andra (EBNA-IgG och VCA-IgG) påvisas i senare skede
Vad tyder detta på?

- Atypiska (aktiverade/Downey cells)/ökat antal lymfocyter (CD8) perifert för att eliminera infekterade B-celler
- Typiskt vid EBV-infektion (mononukleos)
Vad är ett koagulastest?
- Vissa bakterier producerar koagulas, som är ett enzym, som kan ovandla fibrinogen till fibrin, d.v.s. koagulera plasma. Förmågan att producera koagulas anses bl.a. vara kopplat till stafylokockers virulens. Testet används alltså för att skilja på koagulas-positiva (ex aureus) och koagulas-negativa stafylokocker.

Vad är Dnas?
- Typ av enzym som bryter ner nukleinsyra för att bakterien ska kunna använda de ingående nukleotiderna till att bygga upp den egna nukleinsyran. Signifikant för vissa bakterier (ex Staphylococcus aureus)
Hur görs ett DNas-test?
- Bakterier odlas på agarplatta, som innehåller DNA. Om bakterien har DNas bryts DNA ner (över natten)
- Utspädd HCl hälles på plattan, ses klar zon närmast kolonierna eller stryket och en utfällning på resten av plattan är det positivt.
- Detta beror på att de enskilda nukleotiderna är lösliga i utspädd HCl, medan DNA faller ut.

Vilken specifik bakterie kan detta vara?

Escherichia Coli
- Johanna Fredriksson, 10 mån, kommer i sällskap med sin mamma till läkaren på vårdcentralen på grund av feber i tre dagar. Hon har fått febernedsättande medicin med kortvarig effekt.
- Johanna vill inte äta sedan igår kväll och har varit gnällig och hängig. Hon är inte snorig och har inga andra förkylningssymptom. Urinen har vid något tillfälle luktat starkt. Johanna hade en normal förlossning och har tidigare varit helt frisk. Hon bor med mor och far och 4-årig bror.
Stor risk att detta är? Som beror på?
Urinvägsinfektion som beror på Escherichia coli
Lungröntgen av hostande patient:
- Kaviterande infiltrat med ostig nekros-rest. Vad är detta ett tecken på?
Tuberkulos
Vad visar bilden?

- Apiko-posteriort i vänster lungas ovanlob finns ett delvis kaviterat tätt infiltrat, med tunna stråk mot hilusområdet, där det förefaller finnas en förstorad lymfknuta. Det finns dessutom ytterligt glesa stråk mest apikalt på samma sida.
- Bild förenlig med tuberkulos

Trött here (53 år) med svullna lymfkörtlar ljumske. Trombocyter låga och leukocyter mkt högt.
Vad tror du ett blodutstryk visar om det vill sig illa?

Små mogna blaster i överflöd (ja de ska ju inte finnas där), detta tyder på någon typ av lymfatisk leukemi

Förklara DAT, flödescytometrin och IGHV-sekvensen

- DAT - B-celler undertrycker regulatoriska T-celler vilket ökar risken för autoimmunitet mot ex erytrocyter (autoimmun hemolytisk anemi)
- kan prövas med DAT - anti-IgG antikroppar till patientens blodprov så agglutinerar erytrocyterna om de är täckta med IgG autoantikroppar
- Flödescytometrin visar specifika receptorer för vissa typer leukemi
- Överlevnad beroende på genetik gällande IGHV (variabel tung kedja hos B-cell), sämre prognos om den inte är muterad
Akutmottagningen med en 9-årig flicka. På ett födelsedagskalas har hon fått kliande utslag över hela kroppen. Hon blev snabbt blek, illamående och kräktes. Framme vid akutmottagningen rapporterar ambulanspersonalen att flickan, som heter Gabriella Ring, har varit takykard, snabbandad och krävt två liter syrgas för att hålla transkutan syrgasmättnad på 96%.
Vad kan detta handla om?
Anafylaktisk reaktion
Vilken behandling kan vara lämplig vid en anafylaktisk chock?
- Adrenalin
- Bronkodilaterande, vasokonstriktion, hjärtfrekvens och kontraktilitet (blodtryck upp)
- Antihistamin
- Hindrar histamins verkan (klåda, vasodilatation, vätskeutträde)
- Kortison - antiinflammatoriskt
- Verkar genregulativt (hindrar bildlning av ex TNF-alfa, IL-1 och IL-6, även IL-5 som nu inte rekryterar eosinofiler)
- Vätska intravenöst
- Få upp blodtrycket
Etina söker nu vårdcentralen pga. uttalad värk och ömhet i höger fots MTP-led V. Besvären började för c:a 2 veckor sedan. Hon har provat värktabletter (paracetamol), men tycker inte att det hjälpt nämnvärt. Sedan tonåren röker hon ca 10-15 cigaretter om dagen och tar gärna ett glas vin till middagen. Fysisk aktivitet inskränker sig till promenader då och då.
Vad har Etina eventuellt drabbats av?
RA
Vad har denna patient troligen drabbats av?

RA
Ses något patologiskt?


Vätska och inflammationsceller ansamlas i synovium och skapar en förtjockad synovialvävnad
Pannus
Vad bör alltid (utan undantag) en person som drabbats av RA göra?
Sluta röka!


